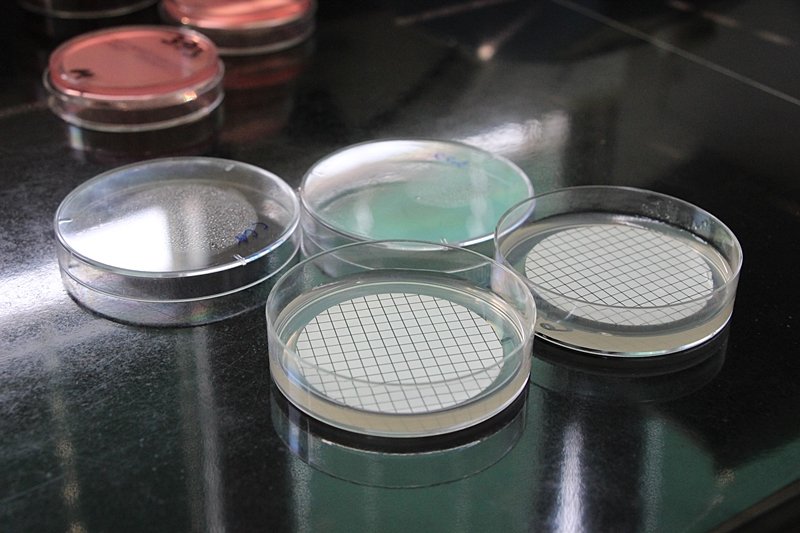
Goran Mratinović

UZELI SMO UZORKE NA DANČAMA Je li čistoća mora zaista ugrožena kao i zdravlje Dubrovčana i njihovih gostiju? (FOTO)
Osim bogate povijesti i kulturnih spomenika, more i sunce su ono što Dubrovnik čini posebnim. Je li čistoća mora zaista ugrožena kao i zdravlje Dubrovčana i njihovih gostiju?
Bili smo na Dančama sa djelatnicima Zavoda za javno zdravstvo Dubrovačko-neretvanske županije kako bi uzeli uzorak mora za analizu, a rezultati su pokazali da je more izvrsne kakvoće. Voditeljica Odjela za okoliš Dolores Grilec objasnila je proces analize, podvukavši kako izvrsna kakvoća znači da nije bilo prisutnosti escherichia coli ili crijevnog enterokoka.

Prisutnost ovih bakterija se mjeri na svim plažama u županiji svakih 14 dana.
Što se ispituje i kako se uzorkuje?
"Ispitiva se prisutnost escherichijhe coli ili crijevnog enterokoka. Granična vrijednost je 300 za e.coli, a 200 za enterokok. Oni su pokazatelji fekalnog onečišćenja. Ne možemo dokazati prisutnost svih bakterija, ali kada utvrdimo da postoji escherichia i enterkok njihova pristunost nam govori da može biti i ostalih bakterija, koje mogu biti i opasnije za ljudsko zdravlje. Ako one nisu pristune, neće biti niti drugih bakterija," objasnila je Grilec te kazala kako se situacije može vrlo brzo promijeniti odnosno prisutnost bakterija povećati ili smanjiti u nekoliko sati. Svi mogu pratiti rezultate testiranja na izor.hr.

"Jedan od kriterija europske komisije da se radi od 4 do 10 ispitivanja u sezoni po plaži, mi ih radimo uglavnom deset," objasnila je Grilec te dodala da kad netko dojavi o iznenadnom onečišćenju mora, izlazi se na teren i uzorkuje se more.
"Ako se ispostavi da je više bakterija nego što to dozvoljavaju granične vrijednosti, onda objavljujemo da je došlo do onečišćenja, izvještavamo nadležni županijski odjel i inspekcijske službe. Uzorkuje se sve do prestanka onečišćenja, recimo takav slučaj je neki dan bio u Srebrenom. Nakon toga opet nakon sedam dana uzimamo uzorak radi provjere," objašnjava Grilec.
Iz Grada Dubrovnika uputili su službeni dopis Zavodu kako žele da se more uzorkuje češće i u popodnevnim satima kao odgovor na zahtjeve građana.
"Mi smo spremni na suradnju i češće uzorkovanje, no treba to razjasniti, odrediti plan financiranja i uzorkovanja - recimo traži li se to samo za plažu Danče ili za sve plaže. To je ipak veliki posao koji izlaz van okvira. Nije posao samo uzeti uzorak. Treba doći u Zavod i pripremiti uzorke, to traje satima," objasnila je Grilec te kaže kako su spremni na suradnju s Gradom, no treba definirati detalje.
Što kada se utvrdi da more nije za kupanje?
Kada se utvrdi da je more onečišćeno, uzorkuje se sve dok onečišćenje ne prođe, a dotad vrijedi zabrana kupanja.
"Važno je znati koja je naša uloga, mi uzorkujemo, analiziramo i interpretiramo te uzorke. Mi apsolutno nemamo nikakvih ovlasti, ne možemo utvrđivati niti sankcionirati tko je počinio nekakvo onečišćenje, to je na inspekciji. Mi smo ti koji se javno izlažemo pa nas ljudi prozivaju, no zaista radimo svoj posao pošteno, a ne možemo rješavati problem kanalizacijskih ispusta ili nešto slično, možemo samo potvrditi onečišćenje," objašnjava Grilec koja tvrdi kako je važno znati postoji li konstantan problem na oderđenoj plaži ili se radi o povremenim onečišćenjima.
Koncesionar dužan obavijestiti kupače
Prema europskoj direktivi koncesionar plaže i/ili jedinice lokalne samouprave dužan je na vidljivim mjestima istaknuti informativne ploče s podacima o kakvoći mora, općem opisu mora za kupanje i informacijama o mogućim izvanrednim događajima na plaži kako bi se postigla bolja informiranost kupača. Grilec se prisjetila slučaja iz 2016.
"Problem je bio kraj Petke prije nekoliko godina, bio je kanalizacijski ispust koji je pukao 2016. Sve je bilo žuto i očajno je izgledalo, mi smo tu našli nekoliko milijuna e.coli na tom mjestu. To je katastrofa i trebalo se prije reagirati. Ono što je dobar pokazatelj, jest da u istom razdoblju Palace i Vis 2 su imali malo preko 300, a svaki dan smo uzorkovali baš ta mjesta. Također smo uzorkovali i Danče i Rixos baš zbog toga i nije bilo onečišćenja. To je dobar znak," tvrdi Grilec.
Osim toga, prošlo ljeto bio je slučaj kada se momak koji je bio instruktor na kajacima zarazio e. coli i imao teških zdravstvenih problema. Iz Zavoda su tada utvrdili onečišćenje, a u suradnji s Vodovodom i Gradom Dubrovnikom ustanovilo se da je nekoliko privatnih kuća bilo ilegalno priključeno na oborinsku odvodnju što je uzrokovalo onečišćenje.
Zavod redovno uzorkuje svako 14 dana, no što kada kupači primjete onečišćenje?
"Recimo, ljudi znaju prijaviti onečišćenje iz doma popodne i kažu 'E, jutros na Lokrumu nije bilo čisto'. To je pogrešno. Onečišćenje se treba prijaviti odmah na licu mjesta, zazvati 112 i objasniti problem. Ako se vidi nekakva mrlja u malom promjeru na velikoj površini koja je čista, to nema smisla. Također, 'cvjetanje mora' ne znači fekalno onečišćenje," kazala je Grilec.
Odakle onečišćenje?
Ipak, iako je na dan kad je Dubrovački dnevnik išao sa djelatnicima Zavoda uzorkovati more na Dančama i ono je bilo izvrsne kakvoće, treba poštivati i glas javnosti odnosno činjenicu da su građani pokrenuli peticiju kojom apeliraju na nadležne službe o postojanju neke vrste onečišćenja u određenim periodima i želju da se problem riješi. Stoga, Dubrovački dnevnik pitao je i upravu Vodovoda iz koje su potvrdili kako tu nema kanalizacijskog sustava.
Direktor Vodovoda Lukša Matušić kazao je kako nestanak struje nema veze s tim onečišćenjem, iako se o tome pisalo i pričalo po društvenim mrežama.
"U Pilama postoje dva transformatora, jedan je u vlasništvu Vodovoda, a drugi HEP-a. Pregorio je HEP-ov koji je opskrbljivao objekte, dok je naš uredno radio i crpna stanica niti u jednom momentu nije bila bez struje, iako su cijele Pile bile bez struje," tvrdi Matušić.
Poslali smo upit sestrama franjevkama na Dančama te pitali je li njihova septička jama nepropusna i čiste li je redovito. Odgovor do zaključenja ovog teksta nismo dobili, a objavit ćemo ga naknadno.